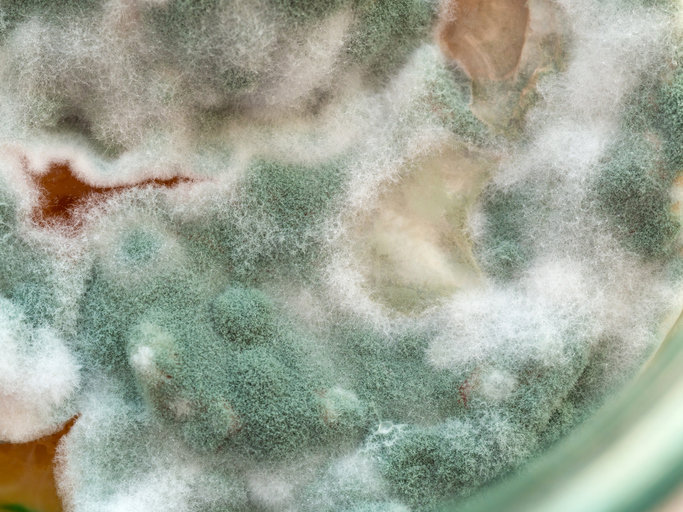

‘투탕카멘의 저주’ 부른 독성물질, 백혈병 특효약 열쇠로
- 동아닷컴
-
입력 2025년 6월 26일 11시 29분
공유하기
글자크기 설정

1922년 이집트 투탕카멘왕의 무덤을 발견했다. 3000년간 잠들어 있던 황금의 관과 가면, 온갖 보석들이 줄줄이 나왔다. 발굴 비용을 지원했던 영국의 카나번 백작이 이 경이로운 매장지를 방문한지 몇 달 만에 사망했다. 발굴에 참여했던 여러 사람이 비슷한 증세를 보이다 죽었다. 미라가 저주를 내렸다는 소문이 돌았다.
1970년대 폴란드에서도 비슷한 일이 있었다. 15세기에 지어진 카지미르 4세의 지하묘지를 발굴했던 12명의 고고학자 중 10명이 같은 운명을 맞았다.
과학이 저주가 아님을 밝혀냈다. 카지미르의 무덤 분석 결과 아스페르길루스 플라부스(Aspergillus flavus)라는 곰팡이가 발견되었는데, 이 곰팡이의 독소는 치명적인 폐 감염을 유발하는 것으로 알려졌다.
학술지 네이처 화학 생물학(Nature Chemical Biology)에 발표한 새로운 연구에 따르면 이 곰팡이가 백혈병 치료에 유망한 것으로 나타났다.
“이것이야말로 자연의 가장 극적인 아이러니이다. 한때 죽음을 가져온다고 두려워했던 동일한 곰팡이가 이제 생명을 구하는 데 도움을 줄 수 있다”라고 교신저자인 셰리 가오(Sherry Gao) 미국 펜실베이니아 대학교 화학·생물분자공학 교수가 말했다.
아스페르길루스 플라부스는 수 세기 동안, 심지어 밀폐된 무덤 안에서도 휴면 상태로 있을 수 있는 포자를 생성한다. 이 곰팡이는 특히 면역 체계가 약한 사람들에게 치명적인 호흡기 감염을 유발할 수 있다.
연구자들은 이 곰팡이가 생성하는 독특한 화합물을 조사하여 RiPPs(리보솜 합성·번역 후 변형된 펩타이드)라고 불리는 자연 화합물의 한 종류를 발견했다. 생물학에서 ‘번역’은 유전정보를 해독해 단백질을 만들어내는 과정을 말한다.
연구자들은 아스페르길루스 플라부스에서 그동안 보고된 적 없는 RiPPs 4종을 발견했다. 네 가지 모두 특이한 맞물린 고리 구조가 공통적으로 존재했으며 아스페리기마이신(asperigimycins)으로 명명했다.
넷 중 두 가지 아스페리기마이신에는 별도의 변형 없이도 강력한 항백혈병 특성이 있다고 연구진은 설명했다. 지난 수십 년간 백혈병 치료에 사용한 미 식품의약국(FDA) 승인 약물인 시타라빈, 다우노루비신과 동일한 수준의 효과라는 평가다.
연구진은 아스페리기마이신이 암세포의 세포 분열 과정을 방해한다는 사실도 알아냈다. 암세포는 정상세포와 달리 비정상적으로 분열한다는 특징이 있다.

무엇보다 기존 화학요법제가 건강한 세포를 손상시킬 위험이 있는 것과 달리 아스페리기마이신은 건강한 조직에 영향을 주지 않고 백혈병 세포의 분열을 선택적으로 방해하는 것으로 보인다.
연구진은 아스페리지마이신을 동물 모델에서 시험할 계획이며, 궁극적으로 인간 대상 임상시험을 목표로 하고 있다.
연구진은 다른 곰팡이 종에도 아스페리기마이신과 유사한 생명을 구할 수 있는 화합물이 숨겨져 있을 가능성이 있다고 믿는다.
“고대 세계는 여전히 현대 의학을 위한 도구를 제공하고 있다. 무덤은 저주로 인해 두려움의 대상이었지만, 이제는 치료법의 원천이 될 수 있다”라고 가오 교수가 말했다.
© dongA.com All rights reserved. 무단 전재, 재배포 및 AI학습 이용 금지
트렌드뉴스
-
1
한동훈 제명 결정, 민주-국힘 지지층 모두 “잘했다” 더 많아
-
2
수명 연장에 가장 중요한 운동법 찾았다…핵심은 ‘이것’
-
3
이정후 美공항서 일시 구금…前하원의장까지 나서 풀려났다
-
4
박근혜 손잡고 울먹인 장동혁 “더 큰 싸움 위해 단식 중단”
-
5
李대통령 지지율 59%…부동산 정책은 “부정적” 47%
-
6
‘대장동 항소 포기’ 반발 검사장 7명 법무연수원 좌천
-
7
與 합당 제안에…조국 “국민 뜻대로” 당내 논의 착수
-
8
트럼프의 그린란드 병합 의지, ‘이 사람’이 불씨 지폈다[지금, 이 사람]
-
9
‘소득 있는 노인’ 노령연금 감액 안한다…월 519만원 미만 대상
-
10
“주차딱지 덕지덕지 뭐냐”…제거비용 200만원 청구한다는 입주민
-
1
수도권급 간-담도-췌장 수술 역량으로 지방 의료 살린다
-
2
한덕수 징역 23년 선고…“위로부터의 내란, 위법성 더 크다”
-
3
박근혜 손잡고 울먹인 장동혁 “더 큰 싸움 위해 단식 중단”
-
4
“장동혁 의식 혼미, 심정지 가능성”…단식 8일째 구급차 대기
-
5
李 “용인 반도체 전력 어디서 해결?…에너지 싼 곳에 갈 수밖에”
-
6
[속보]한덕수 1심 징역 23년 선고…“내란 가담자 중벌 불가피”
-
7
李 “정교유착, 나라 망하는길…‘이재명 죽여라’ 설교하는 교회도”
-
8
[김순덕 칼럼]팥쥐 엄마 ‘원펜타스 장관’에게 700조 예산 맡길 수 있나
-
9
“주차딱지 덕지덕지 뭐냐”…제거비용 200만원 청구한다는 입주민
-
10
[사설]한덕수 구형보다 크게 무거운 23년형… 준엄한 ‘12·3’ 첫 단죄
트렌드뉴스
-
1
한동훈 제명 결정, 민주-국힘 지지층 모두 “잘했다” 더 많아
-
2
수명 연장에 가장 중요한 운동법 찾았다…핵심은 ‘이것’
-
3
이정후 美공항서 일시 구금…前하원의장까지 나서 풀려났다
-
4
박근혜 손잡고 울먹인 장동혁 “더 큰 싸움 위해 단식 중단”
-
5
李대통령 지지율 59%…부동산 정책은 “부정적” 47%
-
6
‘대장동 항소 포기’ 반발 검사장 7명 법무연수원 좌천
-
7
與 합당 제안에…조국 “국민 뜻대로” 당내 논의 착수
-
8
트럼프의 그린란드 병합 의지, ‘이 사람’이 불씨 지폈다[지금, 이 사람]
-
9
‘소득 있는 노인’ 노령연금 감액 안한다…월 519만원 미만 대상
-
10
“주차딱지 덕지덕지 뭐냐”…제거비용 200만원 청구한다는 입주민
-
1
수도권급 간-담도-췌장 수술 역량으로 지방 의료 살린다
-
2
한덕수 징역 23년 선고…“위로부터의 내란, 위법성 더 크다”
-
3
박근혜 손잡고 울먹인 장동혁 “더 큰 싸움 위해 단식 중단”
-
4
“장동혁 의식 혼미, 심정지 가능성”…단식 8일째 구급차 대기
-
5
李 “용인 반도체 전력 어디서 해결?…에너지 싼 곳에 갈 수밖에”
-
6
[속보]한덕수 1심 징역 23년 선고…“내란 가담자 중벌 불가피”
-
7
李 “정교유착, 나라 망하는길…‘이재명 죽여라’ 설교하는 교회도”
-
8
[김순덕 칼럼]팥쥐 엄마 ‘원펜타스 장관’에게 700조 예산 맡길 수 있나
-
9
“주차딱지 덕지덕지 뭐냐”…제거비용 200만원 청구한다는 입주민
-
10
[사설]한덕수 구형보다 크게 무거운 23년형… 준엄한 ‘12·3’ 첫 단죄
-
- 좋아요
- 0개
-
- 슬퍼요
- 0개
-
- 화나요
- 0개



댓글 0